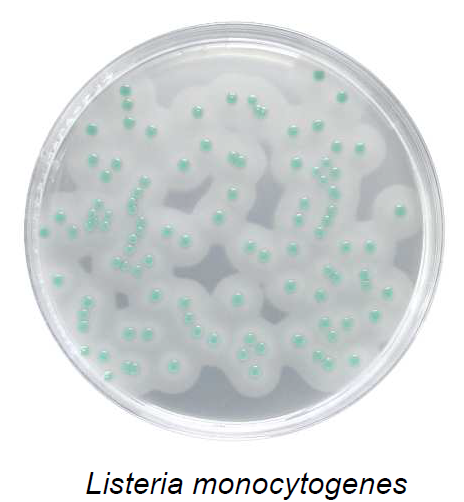

Новости

Merck создает лабораторию сотрудничества с Universitas Indonesia для развития исследований в области наук о жизни
29.04.2021

Системы очистки воды MILLIPORE на платформе Century: программа по замене устаревших систем на особых условиях
08.06.2016

Новое оборудование Mobius® для биофармацевтического производства
05.05.2016
mobius, одноразовые реакторы, биореакторы, одноразовые мешки, ферментаторы

Коннекторы Lynx® CDR для работы со стерильными потоками: новинка от Merck – до 6 асептических сборок с одним устройством
05.05.2016
коннекторы, биореакторы, асептическое соединение, линкс
Агар Listeria по Оттавиани и Агости
10.03.2016
ГОСТ 32031, листерии, listeria monocytogenes, селективная среда на листерии, агар по Оттавиани Агости, ALOA

Отмена лицензирования деятельности по ремонту медицинской техники
02.12.2015
сервис миллипор, техническое обслуживание, лицензия на ремонт медицинской техники

Merck Millipore представляет дополнение к Программе по управлению фармацевтическим сырьем EMPROVE®
02.10.2015
Merck Millipore представляет дополнение к Программе по управлению фармацевтическим сырьем EMPROVE®

Никотин Мерк для производства жидкости для электронных сигарет
17.03.2015
никотин, электронные сигареты, сотка, тысяча, никотин Мерк

Merck усиливает позиции на рынке продукции Life Science в результате присоединения Sigma-Aldrich
29.09.2014
22 сентября 2014 года (Дармштадт, Германия) Мерк объявил о приобретении акций компании Sigma-Aldrich суммарной стоимостью $17.0 миллионов.

Новые насосы Steritest™ Symbio Merck Millipore – несомненное преимущество в контроле стерильности
28.09.2014
Новые насосы Steritest™ Symbio Merck Millipore – несомненное преимущество в контроле стерильности